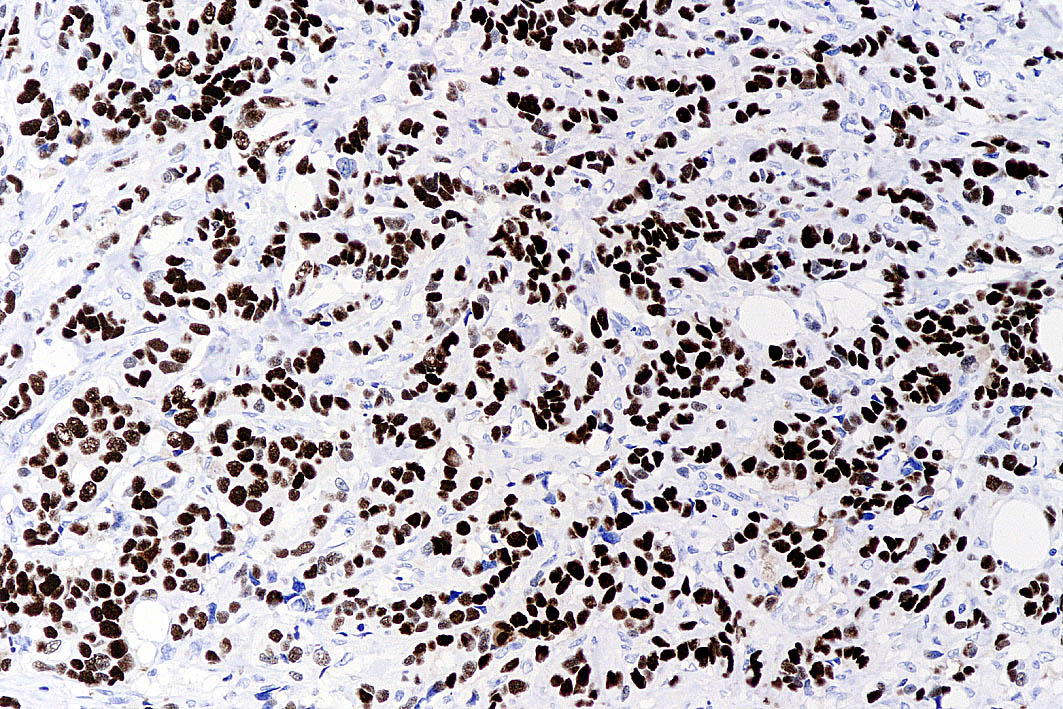
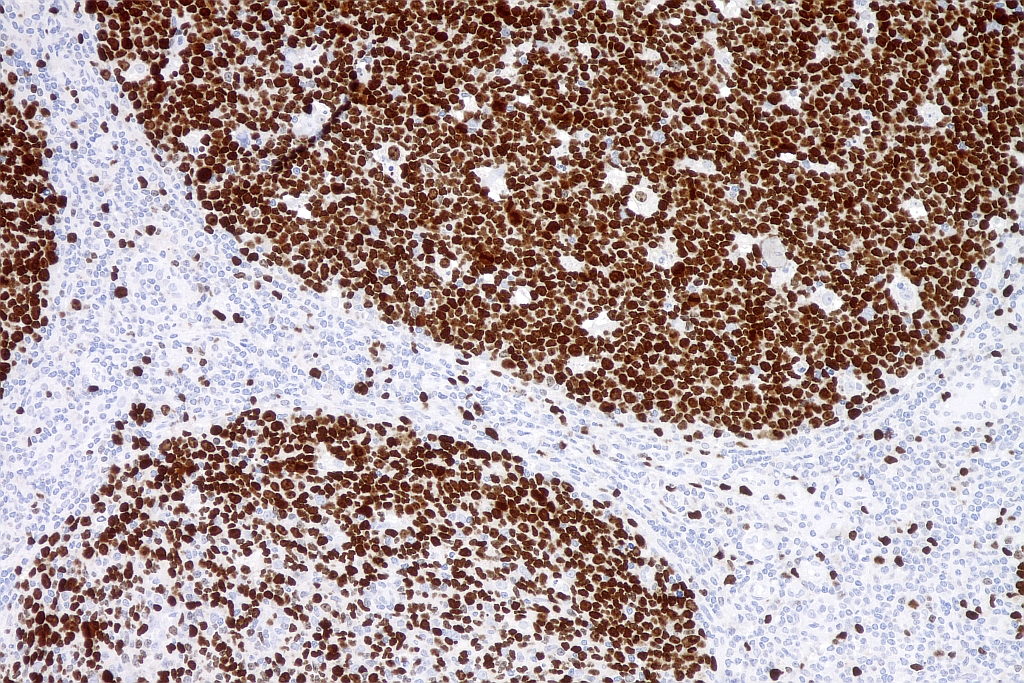
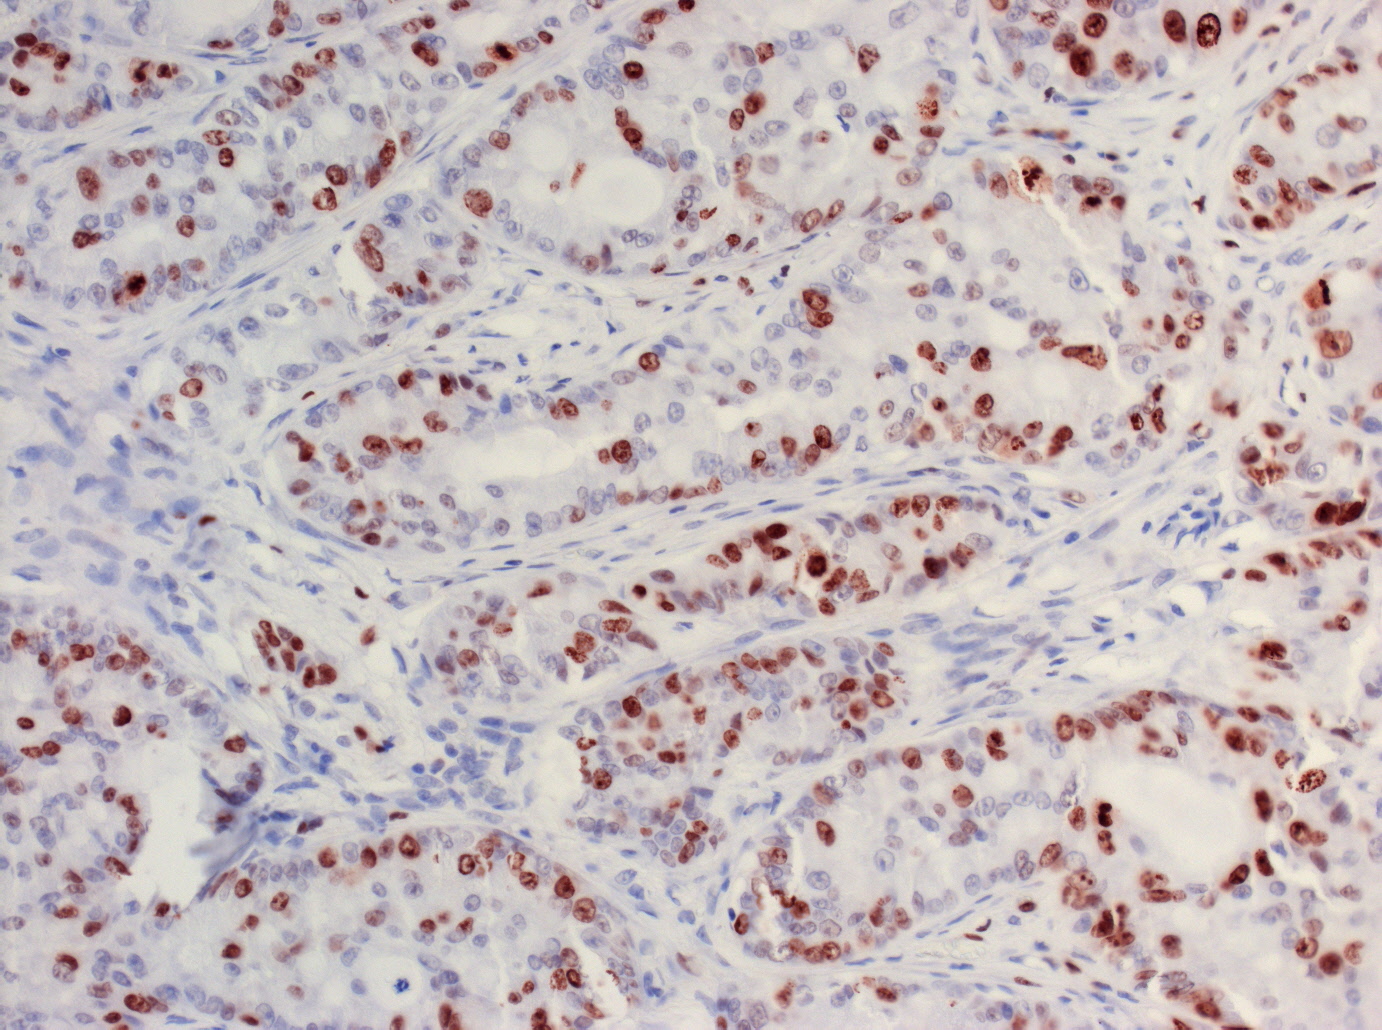

|
|
 |
 |
 |
 |
|
| p63 in squamous carcinoma - mouse monoclonal, AmpliStain™ M1-HRP |
Estrogen receptor in breast carcinoma - mouse monoclonal, AmpliStain™ M1-HRP |
Estrogen receptor in breast carcinoma - rabbit monoclonal, AmpliStain™ R1-HRP |
CD34 in myelodysplastic syndrome-RAEB 1 - mouse monoclonal, AmpliStain™ M1-HRP |
HER2 CISH in a breast carcinoma with HER2 amplification - DIG-labeled HER2 probe, mouse monoclonal, AmpliStain™ M2-HRP |
Ki-67 in a tonsil - mouse monoclonal, AmpliStain™ M1-HRP |
Ki-67 in a tonsil - mouse monoclonal, AmpliStain™ MR2-HRP |
 |
 |
 |
 |
 |
 |
 |
| Estrogen receptor in human mammalian gland - rabbit monoclonal, AmpliStain™ R1-HRP |
desmin - rabbit monoclonal, AmpliStain™ R1-HRP |
Neurofilamental protein - rabbit monoclonal, AmpliStain™ R1-HRP |
 |
 |
 |
|
 |
 |
| S-100 - rabbit monoclonal, AmpliStain™ R1-HRP |
Bcl2 - mouse monoclonal, AmpliStain™ M1-HRP |
CD34 - mouse monoclonal, AmpliStain™ M1-HRP |
MIB1 - mouse monoclonal, AmpliStain™ M1-HRP |
P63 - mouse monoclonal, AmpliStain™ M1-HRP |
vimentin - mouse monoclonal, AmpliStain™ M1-HRP |